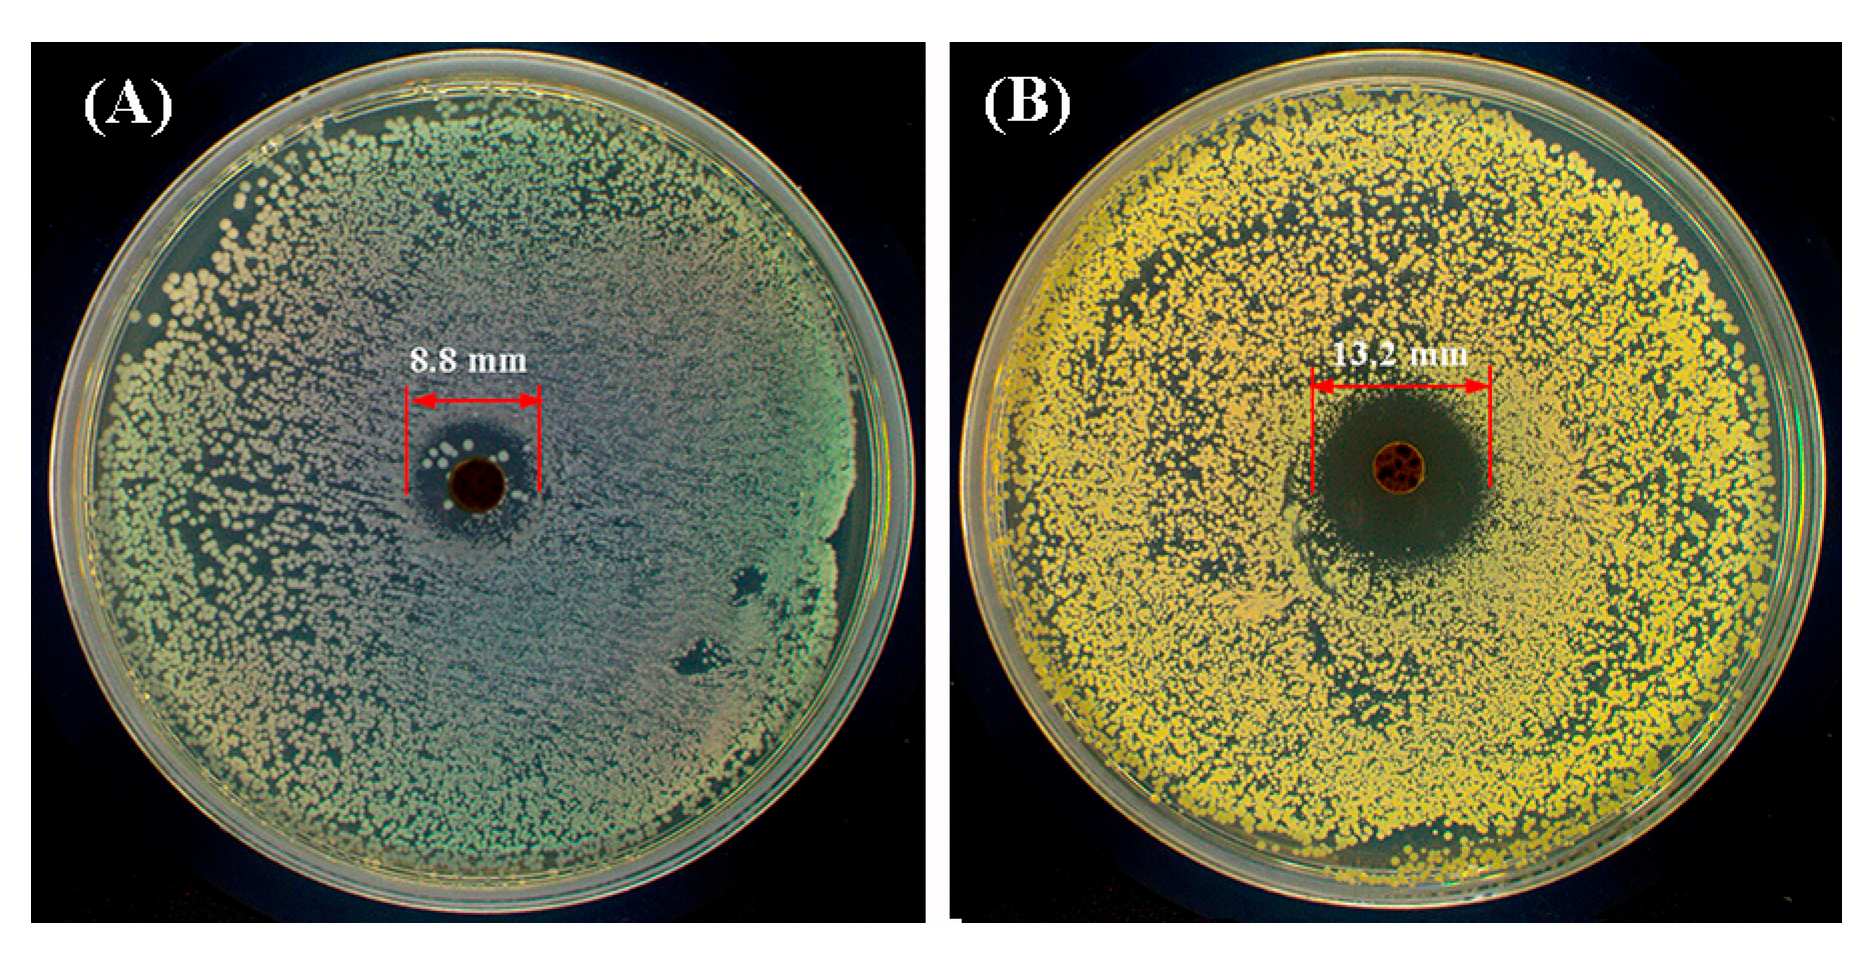
Gels 11 00871 g012

Dual-Crosslinked Gelatin/Dextran Medical Hydrogels Based on Aldimine Condensation and Photopolymerization
Abstract
1. Introduction
2. Results and Discussion
2.1. Formation of GMOD Hydrogels
2.2. FT-IR Spectra
2.3. Microstructure and Porosity
2.4. Thermal Performance
2.5. Surface Wettability and Swelling
2.6. Water-Retention Behavior
2.7. Compressive Performance
2.8. Biodegradability
2.9. Drug Sustained-Release Behavior
2.10. Cytocompatibility
2.11. Hemolysis Assay
2.12. Antibacterial Activity
3. Conclusions
4. Materials and Methods
4.1. Materials
4.2. Synthesis of GelMA
4.3. Synthesis of ODex
4.4. Preparation of GMOD Hydrogels
4.5. Instruments and Characterization
4.5.1. Structural Characterization
4.5.2. Microstructure
4.5.3. Thermal Properties
4.5.4. Surface Water Contact Angle
4.5.5. Swelling Behavior
4.5.6. Water-Retention Capacity
4.5.7. Porosity
4.5.8. Degradability
4.5.9. Compression Test
4.5.10. Drug–Release Behavior
4.5.11. Cytocompatibility Evaluation
4.5.12. Hemolysis
4.5.13. Antibacterial Properties
Supplementary Materials
Author Contributions
Funding
Institutional Review Board Statement
Informed Consent Statement
Data Availability Statement
Conflicts of Interest
References
- Yuan, Y.; Zhang, Q.Q.; Lin, S.M.; Li, J.L. Water: The soul of hydrogels. Prog. Mater. Sci. 2025, 148, 101378. [Google Scholar] [CrossRef]
- Shan, B.H.; Wu, F.G. Hydrogel-based growth factor delivery platforms: Strategies and recent advances. Adv. Mater. 2024, 36, 2210707. [Google Scholar] [CrossRef] [PubMed]
- McClements, D.J. Composite hydrogels assembled from food-grade biopolymers: Fabrication, properties, and applications. Adv. Colloid Interfac. 2024, 332, 103278. [Google Scholar] [CrossRef] [PubMed]
- Rybick, M.; Czajkowska, K.; Grochowska, A.; Białas, B.; Dziatosz, M.; Karolczak, I.; Kot, J.; Wach, R.A.; Kłosiński, K.K. Innovative applications of hydrogels in contemporary medicine. Gels 2025, 11, 798. [Google Scholar] [CrossRef]
- Shahriari, M.H.; Abdouss, M.; Hadjizadeh, A. Synthesis of dual physical self-healing starch-based hydrogels for repairing tissue defects. Polym. Eng. Sci. 2023, 63, 798–810. [Google Scholar] [CrossRef]
- Zhang, M.; Xu, S.; Wang, R.; Che, Y.; Han, C.; Feng, W.; Wang, C.; Zhao, W. Electrospun nanofiber/hydrogel composite materials and their tissue engineering applications. J. Mater. Sci. Technol. 2023, 162, 157–178. [Google Scholar] [CrossRef]
- Wang, Q.L.; Wang, X.Y.; Feng, Y.K. Chitosan hydrogel as tissue engineering scaffolds for vascular regeneration applications. Gels 2023, 9, 373. [Google Scholar] [CrossRef]
- Xiao, Y.; Gu, Y.; Qin, L.; Chen, L.; Chen, X.; Cui, W.; Li, F.; Xiang, N.; He, X. Injectable thermosensitive hydrogel-based drug delivery system for local cancer therapy. Colloids Surf. B 2021, 200, 111581. [Google Scholar] [CrossRef]
- Qiu, H.; Guo, H.; Li, D.; Hou, Y.; Kuang, T.; Ding, J. Intravesical hydrogels as drug reservoirs. Trends Biotechnol. 2020, 38, 579–583. [Google Scholar] [CrossRef]
- Xu, B.; Zhang, Y.; Li, J.; Wang, B.; Li, R.; Cheng, D.; Chang, G. Self-healing PVA/chitosan/mxene triple network hydrogel for strain and temperature sensors. Int. J. Biol. Macromol. 2025, 290, 138811. [Google Scholar] [CrossRef]
- Maiti, S.; Maji, B.; Yadav, H. Progress on green crosslinking of polysaccharide hydrogels for drug delivery and tissue engineering applications. Carbohyd. Polym. 2024, 326, 121584. [Google Scholar] [CrossRef] [PubMed]
- Liu, Y.; Song, S.; Liu, S.; Zhu, X.; Wang, P. Application of nanomaterial in hydrogels related to wound healing. J. Nanomater. 2022, 2022, 4656037. [Google Scholar] [CrossRef]
- Zainal, S.H.; Mohd, N.H.; Suhaili, N.; Anuar, F.H.; Lazim, A.M.; Othaman, R. Preparation of cellulose-based hydrogel: A review. J. Mater. Res. Technol. 2021, 10, 935–952. [Google Scholar] [CrossRef]
- Zhang, Y.; Wang, Y.; Li, Y.; Yang, Y.; Jin, M.; Lin, X.; Zhuang, Z.; Guo, K.; Zhang, T.; Tan, W. Application of collagen-based hydrogel in skin wound healing. Gels 2023, 9, 185. [Google Scholar] [CrossRef]
- Song, H.; Xing, L.; Liu, W.; Wang, X.; Hou, Z.; Wang, Y.; Zhang, Z.; Li, Y.; Li, T.; Wang, X.; et al. Biomimetic and multifunctional hemostatic hydrogel with rapid thermoresponsive gelation and robust wet adhesion for emergency hemostasis: A rational design based on photo-cross-linking coordinated hydrophilic−hydrophobic balance strategies. Biomacromolecules 2023, 24, 3327–3344. [Google Scholar] [CrossRef]
- Dong, Y.; Cui, M.; Qu, J.; Wang, X.; Kwon, S.H.; Barrera, J.; Elvassore, N.; Gurtner, G.C. Conformable hyaluronic acid hydrogel delivers adipose-derived stem cells and promotes regeneration of burn injury. Acta Biomater. 2020, 108, 56–66. [Google Scholar] [CrossRef]
- Du, Y.; Xu, Y.; Hou, J.; Li, X.; Yang, J.; Yang, J.; Shan, S.; Wang, C.; Su, H. Robust fabrication of pyrogallol-conjugated dextran hydrogel as antioxidant hemo-adsorbent for the selective adsorption of Pb(II). Sep. Purif. Technol. 2025, 363, 132098. [Google Scholar] [CrossRef]
- Wang, S.; Yang, Q.; Xu, J.; Zhou, Y.; Tian, X.; Wu, W.; Elango, J.; Diao, X. Biofunctional carboxymethyl chitosan hydrogel incorporating hyaluronic acid and RGD peptides for accelerated wound repair. Gels 2025, 11, 765. [Google Scholar] [CrossRef]
- Arif, M.; Raza, H.; Moussa, S.B.; Alzahrani, A.Y.A.; Akhter, T. Poly (chitosan-N-vinylcaprolactam-methacrylic acid) microgels as microreactor for Ag(I) ions extraction and in-situ silver nanoparticles formation to reduce the toxins. Int. J. Biol. Macromol. 2024, 282, 136906. [Google Scholar] [CrossRef]
- Fan, Z.; Cheng, P.; Zhang, P.; Zhang, G.; Han, J. Rheological insight of polysaccharide/protein based hydrogels in recent food and biomedical fields: A review. Int. J. Biol. Macromol. 2022, 222, 1642–1664. [Google Scholar] [CrossRef] [PubMed]
- Geng, J.; Zhou, G.; Guo, S.; Wang, G.; Ma, J.; Ma, C. Dextran based dual-dynamic-network hydrogel for chronic wound healing with mechanically adaptive, antibacterial, and pH-responsive drug delivery. Int. J. Biol. Macromol. 2025, 322, 144865. [Google Scholar] [PubMed]
- Delvart, A.; Moreau, C.; Cathala, B. Dextrans and dextran derivatives as polyelectrolytes in layer-by-layer processing materials—A review. Carbohydr. Polym. 2022, 293, 119700. [Google Scholar] [CrossRef]
- Zhu, S.; Yu, C.; Liu, N.; Zhao, M.; Chen, Z.; Liu, J.; Li, G.; Huang, H.; Guo, H.; Sun, T.; et al. Injectable conductive gelatin methacrylate/oxidized dextran hydrogel encapsulating umbilical cord mesenchymal stem cells for myocardial infarction treatment. Bioact. Mater. 2022, 13, 119–134. [Google Scholar] [CrossRef]
- Seera, S.D.K.; Kundu, D.; Gami, P.; Naik, P.K.; Banerjee, T. Synthesis and characterization of xylan-gelatin cross-linked reusable hydrogel for the adsorption of methylene blue. Carbohyd. Polym. 2021, 256, 117520. [Google Scholar]
- Han, S.; Tan, H.; Wei, J.; Yuan, H.; Li, S.; Yang, P.; Mi, H.; Liu, C.; Shen, C. Surface modification of super arborized silica for flexible and wearable ultrafast-response strain sensors with low hysteresis. Adv. Sci. 2023, 10, 2301713. [Google Scholar] [CrossRef]
- Xu, X.; Jerca, V.V.; Hoogenboom, R. Bioinspired double network hydrogels: From covalent double network hydrogels via hybrid double network hydrogels to physical double network hydrogels. Mater. Horiz. 2021, 8, 1173–1188. [Google Scholar]
- Wang, L.; Cheng, L.; Chen, Y.; Zhai, H.; Chen, Z.; Ren, T.; Xu, L.; Ding, J.; Qiu, J.; Hua, K.; et al. Dual-crosslinked bioactive hydrogel scaffold for accelerated repair of genital tract defect. Adv. Funct. Mater. 2024, 34, 2405966. [Google Scholar]
- Choi, S.; Jo, J.; Park, J.; Kim, S.; Jeong, S.; Jeong, S.Y.; Jung, S.H.; Choi, E.; Kim, H. Stimuli-responsive, methyl cellulose-based, interpenetrating network hydrogels: Non-covalent design, injectability, and controlled release. Carbohyd. Polym. 2025, 347, 122689. [Google Scholar]
- Tan, J.; Li, J.; Zhang, Y.; Li, X.; Han, S.; Li, Z.; Zhou, X. Application of photocrosslinked gelatin, alginate and dextran hydrogels in the in vitro culture of testicular tissue. Int. J. Biol. Macromol. 2024, 260, 129498. [Google Scholar] [CrossRef] [PubMed]
- Zheng, Y.; Cui, T.; Wang, J.; Hu, Y.; Gui, Z. Engineering robust and transparent dual-crosslinked hydrogels for multimodal sensing without conductive additives. J. Colloid Interf. Sci. 2024, 675, 14–23. [Google Scholar]
- Hou, P.; Zhang, N.; Wu, R.; Xu, W.; Hou, Z. Photo-cross-linked biodegradable hydrogels based on n-arm-poly(ethylene glycol), poly(ε-caprolactone) and/or methacrylic acid for controlled drug release. J. Biomater. Appl. 2017, 32, 511–523. [Google Scholar]
- He, Y.; Yang, W.; Zhang, C.; Yang, M.; Yu, Y.; Zhao, H.; Guan, F.; Yao, M. ROS/pH dual responsive PRP-loaded multifunctional chitosan hydrogels with controlled release of growth factors for skin wound healing. Int. J. Biol. Macromol. 2024, 258, 128962. [Google Scholar] [PubMed]
- Pulidori, E.; Micalizzi, S.; Koutsomarkos, N.; Bramanti, E.; Tinè, M.R.; Vozzi, G.; Maria, C.D.; Chatzinikolaidou, M.; Duce, C. Analysis of gelatin secondary structure in gelatin/keratin-based biomaterials. J. Mol. Struct. 2023, 1279, 134984. [Google Scholar]
- Qiao, L.; Liu, C.; Liu, C.; Zong, L.; Gu, H.; Wang, C.; Jian, X. Self-healing, pH-sensitive and shape memory hydrogels based on acylhydrazone and hydrogen bonds. Eur. Polym. J. 2022, 162, 110838. [Google Scholar]
- Liu, Z.; Chen, L.; Qu, L.; Zhang, R.; Qin, Z.; Zhang, H.; Wei, J.; Xu, J.; Hou, Z. Cross-linked poly(ester urethane)/starch composite films with high starch content as sustainable food-packaging materials: Influence of cross-link density. Int. J. Biol. Macromol. 2024, 256, 128441. [Google Scholar] [CrossRef] [PubMed]
- Vanin, F.M.; Sobral, P.J.A.; Menegalli, F.C.; Carvalho, R.A.; Habitante, A.M.Q.B. Effects of plasticizers and their concentrations on thermal and functional properties of gelatin-based films. Food Hydrocolloid. 2005, 19, 899–907. [Google Scholar]
- Karydis-Messinis, A.; Moschovas, D.; Markou, M.; Gkantzou, E.; Vasileiadis, A.; Tsirka, K.; Gioti, C.; Vasilopoulos, K.C.; Bagli, E.; Murphy, C.; et al. Development, physicochemical characterization and in vitro evaluation of chitosan-fish gelatin-glycerol hydrogel membranes for wound treatment applications. Carbohydr. Polym. Tech. 2023, 6, 100338. [Google Scholar]
- Tang, Q.; Jiang, J.; Li, J.; Zhao, L.; Xi, Z. Effects of chemical composition and cross-linking degree on the thermo-mechanical properties of bio-based thermosetting resins: A molecular dynamics simulation study. Polymers 2024, 16, 1229. [Google Scholar] [CrossRef]
- Zheng, E.; Zhang, P.; Wang, J.; Chen, Y.; Liu, H.; Xu, J.; Hou, Z. Dual dynamic bonds enable biocompatible polyurethane hydrogels with superior toughness, fatigue and puncture resistance, pH-reversibility, and room-temperature self-healability. Polymer 2025, 327, 128381. [Google Scholar] [CrossRef]
- Wessely, I.D.; Matt, Y.; An, Q.; Bräse, S.; Tsotsalas, M. Dynamic porous organic polymers with tuneable crosslinking degree and porosity. RSC Adv. 2021, 11, 27714–27719. [Google Scholar] [CrossRef]
- Gao, W.; Chang, J.; Li, X.; Li, S.; Zhou, Y.; Hou, X.; Long, L.; Zhao, J.; Yuan, X. A quenched double-hydrophilic coating for the enhancement of water retention of hydrogels. Adv. Funct. Mater. 2023, 33, 2303306. [Google Scholar] [CrossRef]
- Nakajima, T.; Kurokawa, T.; Ahmed, S.; Wu, W.L.; Gong, J.P. Characterization of internal fracture process of double network hydrogels under uniaxial elongation. Soft Matter 2013, 9, 1955–1966. [Google Scholar] [CrossRef]
- Ding, X.; Yang, B.; Hou, Z. In situ crosslinked biodegradable hydrogels based on poly(ethylene glycol) and poly(ε-lysine) for medical application. Molecules 2024, 29, 5435. [Google Scholar] [CrossRef]
- Piazza, R.D.; Brandt, J.V.; Santos, C.C.D.; Marques, R.F.C.; Junior, M.J. Gelatin/dextran-based hydrogel cross-linked by Diels–Alder click chemistry: The swelling and potassium diclofenac releasing. Med. Devices Sens. 2021, 4, e10151. [Google Scholar] [CrossRef]
- GB/T 16886.1-2022; Biological Evaluation of Medical Devices. Part 1: Evaluation and Testing within a Risk Management Process. Standards Press of China: Beijing, China, 2022.
- Liu, Z.; Qin, Z.; Jia, H.; Xu, J.; Liu, M.; Hou, Z. Dual-crosslinked starch-poly(ester urethane)-oligochitosan films with high starch content: Application as biodegradable food packaging. Food Packag. Shelf 2023, 37, 101064. [Google Scholar] [CrossRef]
- Zhou, H.Y.; Zhang, Y.P.; Zhang, W.F.; Chen, X.G. Biocompatibility and characteristics of injectable chitosan-based thermosensitive hydrogel for drug delivery. Carbohyd. Polym. 2011, 83, 1643–1651. [Google Scholar] [CrossRef]
- Kalaycıoglu, Z.; Emrah, T.; Güls, A.E.; Ilhan, Ö.; Bedia, F.E. Antimicrobial and physical properties of chitosan films incorporated with turmeric extract. Int. J. Biol. Macromol. 2017, 101, 882–888. [Google Scholar] [CrossRef] [PubMed]
- Singh, B.; Sharma, S.; Dhiman, A. Transdermal patches: A recent approach to new drug delivery system. Int. J. Pharmaceut. 2013, 457, 82–91. [Google Scholar] [CrossRef]
- Mirbagheri, V.S.; Alishahi, A.; Ahmadian, G.; Petroudi, S.H.H.; Ojagh, S.M.; Romanazzi, G. Toward understanding the antibacterial mechanism of chitosan: Experimental approach and in silico analysis. Food Hydrocolloid. 2024, 147, 109382. [Google Scholar] [CrossRef]
- Li, W.; Xu, K.; Liu, Y.; Lei, X.; Ru, X.; Guo, P.; Feng, H.; Chen, Y.; Xing, M. Hydrophobic polystyrene-modified gelatin enhances fast hemostasis and tissue regeneration in traumatic brain injury. Adv. Healthc. Mater. 2023, 12, 2300708. [Google Scholar] [CrossRef]
- Hoch, E.; Schuh, C.; Hirth, T.; Tovar, G.E.M.; Borchers, K. Stiff gelatin hydrogels can be photo-chemically synthesized from low viscous gelatin solutions using molecularly functionalized gelatin with a high degree of methacrylation. J. Mater. Sci. Mater. Med. 2012, 23, 2607–2617. [Google Scholar] [CrossRef] [PubMed]
- Shirahama, H.; Lee, B.H.; Tan, L.P.; Cho, N.J. Precise tuning of facile one-pot gelatin methacryloyl (GelMA) synthesis. Sci. Rep. 2016, 6, 31036. [Google Scholar] [CrossRef] [PubMed]
- Zhang, Y.; Ding, Z.; Liu, Y.; Zhang, Y.; Jiang, S. White-light-emitting hydrogels with self-healing properties and adjustable emission colors. J. Colloid Interf. Sci. 2021, 582, 825–833. [Google Scholar] [CrossRef] [PubMed]
- Zhao, H.; Heindel, N.D. Determination of degree of substitution of formyl groups in polyaldehyde dextran by the hydroxylamine hydrochloride method. Pharm. Res. 1991, 8, 400–402. [Google Scholar] [CrossRef]

Disclaimer/Publisher’s Note: The statements, opinions and data contained in all publications are solely those of the individual author(s) and contributor(s) and not of MDPI and/or the editor(s). MDPI and/or the editor(s) disclaim responsibility for any injury to people or property resulting from any ideas, methods, instructions or products referred to in the content. |
© 2025 by the authors. Licensee MDPI, Basel, Switzerland. This article is an open access article distributed under the terms and conditions of the Creative Commons Attribution (CC BY) license (https://creativecommons.org/licenses/by/4.0/).
Share and Cite
Ding, X.; Yang, B.; Ni, L.; Niu, G.; Si, X.; Lu, N.; Hou, Z. Dual-Crosslinked Gelatin/Dextran Medical Hydrogels Based on Aldimine Condensation and Photopolymerization. Gels 2025, 11, 871. https://doi.org/10.3390/gels11110871
Ding X, Yang B, Ni L, Niu G, Si X, Lu N, Hou Z. Dual-Crosslinked Gelatin/Dextran Medical Hydrogels Based on Aldimine Condensation and Photopolymerization. Gels. 2025; 11(11):871. https://doi.org/10.3390/gels11110871
Chicago/Turabian StyleDing, Xia, Bing Yang, Lei Ni, Guangliang Niu, Xinyi Si, Ning Lu, and Zhaosheng Hou. 2025. "Dual-Crosslinked Gelatin/Dextran Medical Hydrogels Based on Aldimine Condensation and Photopolymerization" Gels 11, no. 11: 871. https://doi.org/10.3390/gels11110871
APA StyleDing, X., Yang, B., Ni, L., Niu, G., Si, X., Lu, N., & Hou, Z. (2025). Dual-Crosslinked Gelatin/Dextran Medical Hydrogels Based on Aldimine Condensation and Photopolymerization. Gels, 11(11), 871. https://doi.org/10.3390/gels11110871






